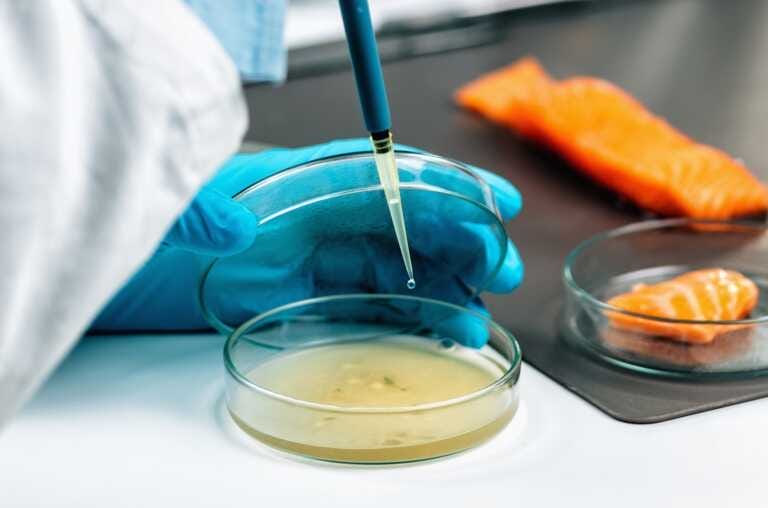

Cooperare negli ambiti della ricerca, della conoscenza e dell’innovazione: sono gli obiettivi del protocollo d’intesa siglato da Lum Strategy Innovation, impresa di servizi attiva nel settore dell’innovazione strategica, e FoodInnLab, azienda che fornisce servizi di auditing, consulenze in materia di sicurezza alimentare e analisi chimiche, fisiche, microbiologiche, molecolari e ambientali. La partnership tra Lum Strategy Innovatione FoodInnLab si articolerà in una serie di azioni.
Il protocollo
In primo luogo, le aziende realizzeranno progetti di ricerca con l’obiettivo di sviluppare nuove conoscenze e soluzioni innovative nei rispetti ambiti; poi provvederanno allo sviluppo di questionari per i clienti, in modo tale da analizzare le esigenze del mercato e migliorare i prodotti offerti, e organizzare conferenze, workshop e seminari, con l’obiettivo di promuovere le competenze e aumentare la visibilità sul mercato.
L’intesa appena stipulata, infine, prevede che le due aziende si segnalino reciprocamente i clienti e strutturino offerte complementari. «Il protocollo d’intesa rappresenta una tappa importante del percorso di crescita della nostra azienda – sottolinea Cesare Pinto, amministratore delegato di FoodInnLab – La partnership con una società, che da tempo collabora col mondo universitario e può contare su un nutrito panel di professionisti esperti, contribuirà a migliorare ulteriormente la qualità dei servizi offerti da una realtà come la nostra che ambisce ad affermarsi come leader nel settore».